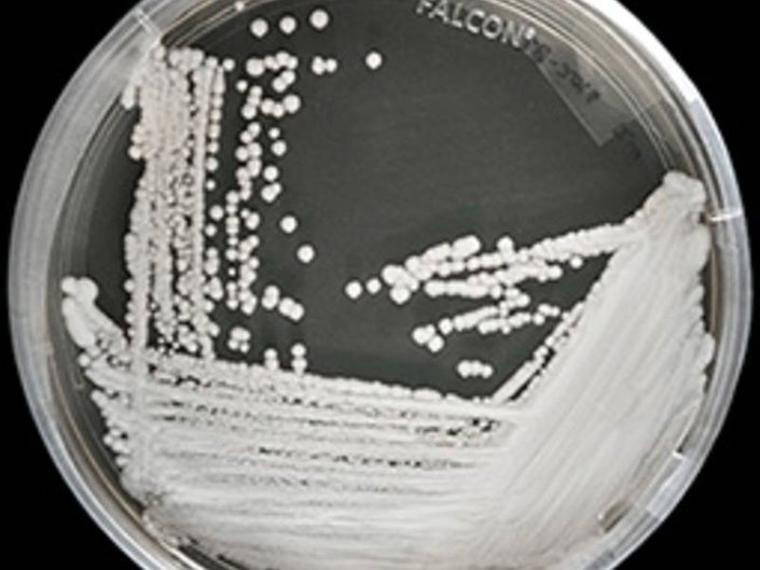
Ölümcül mantar yayılıyor

Bilim insanları uyarıyor: Günümüzde kullanılan tedavi yöntemlerine karşı bağışıklığı olan ve nasıl durduracağımızı bilmediğimiz bir mantar türü dünya genelinde yayılıyor. Antimikrobiyal ilaçlara dirençli ölümcül bir mantar enfeksiyonu olarak bilinen Candida auris’ten bahsediyoruz. Ve bu mantarın nereden geldiği de tam bir muamma. Yapılan araştırmalara göre, bu mantar İngiltere, İspanya, Hindistan, Venezüella ve ABD de dahil olmak üzere tüm dünyada ilaca dirençli bir mantar türü olarak ortaya çıktı.
Hastalık Kontrol ve Önleme Merkezleri’ne (CDC) göre bu mantar, normalde cilt ve mukoza zarlarında yaşayan zararsız bir mayaydı. Ancak ilaca direnç göstermeye başlamalarıyla birlikte işler tersine döndü. Bu mantar için “siyah lagünün yarattığı bir yaratık” diyen CDC Direktörü Tom Chiller, “artık her yerde” diye uyarıyor. Basitçe söylemek gerekirse, mantarlar, tıpkı bakteriler gibi, modern ilaçlardan kurtulmak için savunma geliştiriyor. Ve bu durum, modern tıbbın karşı karşıya olduğu en büyük problemlerin başında geliyor.
Büyüyen tehdit
CDC ilk olarak 2016’da ilaca dirençli C. auris hakkında bir uyarı yayımlamıştı ve kurum, bu mantarı bugün “ciddi bir tehdit” olarak nitelendiriyor. Söz konusu uyarıya göre, maya ilk olarak 2009’da Japonya’daki bir hastanın kulak akıntısında ortaya çıktı, ancak eski tıbbi örneklerin kapsamlı bir incelemesi sonucunda enfeksiyonun geçmişinin Güney Kore’de 1996’ya kadar uzandığı ortaya çıktı. CDC’ye göre C.auris türleri, en az bir antifungal ilaç sınıfına karşı dirençli ve türlerin üçte birinden fazlası iki ilaç sınıfına dayanıklı. Bir tür alt kümesi ise mevcut üç antifungal ilaç sınıfının hepsine karşı dirençli. Bu da bu mantarın tedavisini güçleştirdiği gibi yayılmasının da önüne geçemiyor. Bu enfeksiyonu daha da endişe verici kılan husus ise mantarın hastane ve klinik yüzeylerinde bulunması ve kişiden kişiye yayılması.
ABD’de Chicago bölgesindeki bazı huzurevlerinde test edilen hastaların yarısında C. auris pozitif çıktı. Şimdiye kadar, Amerika Birleşik Devletleri’nde 587 vaka raporu kayıtlara geçti. C. auris enfeksiyonları, yaşlılar ve gençler de dahil olmak üzere, bağışıklık sistemine zarar verme kapasitesi açısından en ölümcül türler arasında. Enfeksiyon tipik olarak sağlık hizmetleri verilen ortamlarda yayılıyor. İlk belirtileri ateş, ağrı ve halsizlik olup mayası kana, beyine veya kalbe yayılırsa hastalık ölümcül olabiliyor.
Virüsün yayılma nedeni: Endüstriyel tarım yöntemleri ve antibiyotikler
İlaca dirençli C. auris türleri, farklı kıtalarda genetik olarak çeşitlilik gösteriyor ve bu, ilaç direncinin ayrı ayrı fakat aynı anda dünya çapında geliştiğini gösteriyor. Bu mantar “süper böceklerde” söz konusu artışa neyin neden olduğu ise halen belirsiz, ancak bir teoriye göre ekinlerde yaygın fungisit (mantarla mücadele ilaçları) kullanımı C. auris’in direnç geliştirmesini teşvik etti. Buna paralel olarak çiftlik hayvanlarında aşırı antibiyotik kullanımı, antibiyotiğe dirençli bakterilerde de benzer bir kriz yaratmıştı. Yani mantarların tehlikeli hale gelmesinin suçlusu -büyük ihtimalle- endüstriyel tarım yöntemleri ve antibiyotikler.
Her şekilde yaşıyor
PLOS Pathogens dergisinde yer alan 2012 araştırmasına göre, azol olarak adlandırılan mantar öldürücüler, ilaca dirençli başka bir mantar olan Aspergillus fumigatus’un da dirençli hale gelmesine neden olmuştu. Bazı araştırmacılar, aynı antifungallerin, C. auris’i de ilaca karşı dirençli kılarak hayatta kalmalarına ve yayılmalarına katkıda bulunmuş olabileceğini öne sürüyor. CDC, şimdilerde C. auris’in genetiğini izlemek ve yayılmasının nasıl durduracağını anlamak için çalışıyor. The New Times’daki habere göre, bu zor olabilir. Gazeteye göre, Londra yakınlarındaki Royal Brompton Hastanesi’nde çalışanlar, tüm odada hidrojen peroksit ve mikropları kırmak için özel spreyler kullandılar. Her şey öldü, - C. auris hariç.